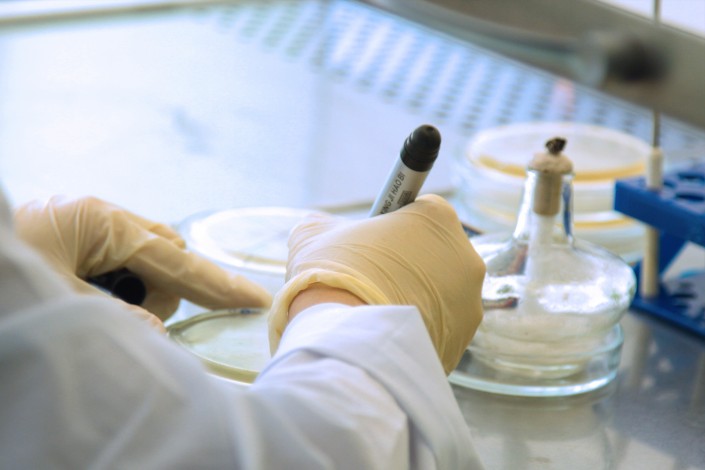

Специалисты алматинской лаборатории исследуют бактерии менингококка. Как проходит работа в лаборатории? Как обследуют контактных лиц и зачем специалисты "выращивают" болезнетворные бактерии? Корреспондент Tengrinews.kz посетил филиал РГП на ПХВ "Национальный центр экспертизы" в Алматы и узнал ответы на эти вопросы.
Ничем не примечательное пятиэтажное здание в центре города. Именно здесь находится лаборатория Национального центра экспертизы.

Сюда направляют людей, которые контактировали с больными менингококком. Здесь же обследуют на носительство менингококковой инфекции. Направление на обследование каждого контактного лица дает Департамент общественного здоровья. В связи с последними событиями с менингитом лаборатория работала в авральном режиме. На менингококк обследовано более пяти тысяч человек только в Алматы.

Фото ©Tengrinews.kz
Как поясняют специалисты Центра, обследуются люди из очагов возможного распространения. Проверкой уже зараженных лиц занимаются в инфекционной больнице.
"Мы уже три месяца в авральном режиме работаем. С момента регистрации первого в этом году случая обследовали 5 053 контактных лица. Из этого числа выявили 16 носителей, список отправили в Департамент. Работали без выходных, в день иногда по сто человек приходили", - рассказывает начальник отдела экспертной деятельности Центра Бахыт Кантарбаев.

Бахыт Кантарбаев
Само обследование происходит следующим образом. Сначала у человека, который пришел на обследование, берут пробу биологического материала. Поскольку "входными воротами" инфекции являются слизистые оболочки верхних дыхательных путей, материал на исследование берется мазком с носоглотки с помощью специального стерильного тампона.

Процедура эта очень быстрая и совершенно безболезненная. После того как материал оказался на тампоне, он переносится в специальную среду. Это необходимо для того, чтобы бактерии, если они там есть, начали "расти".
"Это ведь микроорганизм, и его очень трудно заметить. Микрофлоры в горле очень много, и чтобы понять, есть ли там те бактерии, которые мы ищем, нужно эти бактерии вырастить, как выращивают ребенка", - поясняет специалист лаборатории.
Работа по исследованию проводится в стерильном помещении. Вход посторонним туда строго воспрещен, и все сотрудники работают в защитных костюмах. Кроме того, работники лаборатории регулярно проходят медицинские осмотры, так как им приходится работать с опасными бактериями и вирусами.


Затем бактерии переносятся в специальные чашки. Они уже прошли обработку, и в них содержится питательный состав из животной сыворотки. В такой среде бактерии менингококка очень хорошо размножаются что нужно для того, чтобы их идентифицировать.


После того как пробы помещены, или "засеяны", в питательную среду, сосуды помещаются в специальный шкаф - термостат, где поддерживается определенная температура, необходимая для комфортного роста бактерий.

Здесь бактерии хранятся в течение нескольких дней. Термостат поддерживает комфортную температуру, которая позволяет бактериям быстро развиваться.

В термостате бактерии выращиваются сутки, после чего специалисты исследуют каждый из контейнеров.

Каждая из чашек очень внимательно рассматривается, так как каждому типу бактерий присущ свой характерный вид. Образцы рассматриваются каждый день в течение четырех суток.


Так бактерии менингококка выглядят по микроскопом. (Иллюстративное фото: kn.ks.ua)
"Процесс идентификации очень сложный. Вы видели, как растет плесень, это что-то похожее. Только у бактерий менингококка растущие колонии имеют свой характерный рисунок, и это мы как раз должны увидеть. Также здесь определяется тип менингита", - пояснили специалисты.
После того как каждый образец будет проверен, результаты исследований отправляются к санэпидемиологам.
Также в Центре экспертизы прокомментировали заявление алматинского Департамента охраны общественного здоровья о том, что их специалисты якобы своевременно не выявили носителей менингококковой инфекции, в связи с чем не удалось предупредить ее распространение.

Фото ©Tengrinews.kz
"Мы не можем выполнять задачи выше своих компетенций. В соответствии с приказом № 126 нам поставили задачу - провести исследование контактных лиц, мы ее выполнили. Тот список, который нам был предоставлен Департаментом, мы обследовали и о результатах проверки своевременно доложили. Плановая работа нами была своевременно проведена", - заявили в Центре.
Напомним, с начала этого года в Казахстане, по данным Министерства здравоохранения, зарегистрировано 60 случаев менингококковой инфекции. Из них 13 случаев с летальным исходом. В Алматы и Алматинской области скончались десять человек, двое - в Южно-Казахстанской области и один - в Кызылординской. Еще двое больных с подозрением на менингококковую инфекцию зарегистрированы 11 июня, а несколько дней назад диагноз подтвердился у ребенка в Актюбинской области.